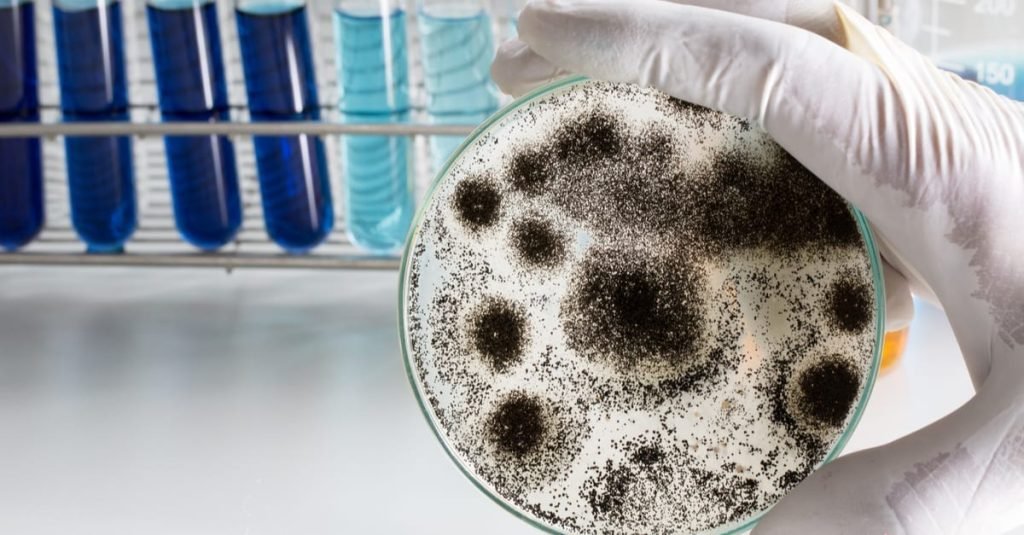
How To Clean Mold Out Of Ice Maker

How to Clean Lice Comb And Brushes
To clean lice combs and brushes, soak them in hot water and then remove any remaining lice or debris with a fine-toothed comb and a brush cleaner. Once clean, rinse the tools thoroughly and allow them to air dry. Taking care of personal hygiene and ensuring cleanliness is essential, especially when it comes to dealing with lice infestation. Lice combs and brushes can easily become breeding grounds for these parasites, so it is crucial to […]
How to Clean Lice Comb And Brushes Read More »